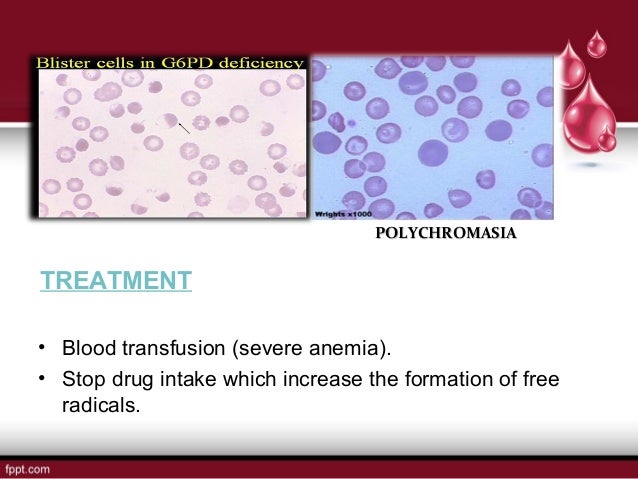

- Complete blood count (CBC). This test measures many different parts of your blood.
- Other blood tests. If the CBC test shows that you have anemia, you may have other blood tests. ...
- Urine test. ...
- Bone marrow aspiration or biopsy.
Explore
These tests may include:
- A reticulocyte count to see if your bone marrow is making red blood cells at an accelerated rate (this is a sign of prior blood loss)
- Serum iron and ferritin tests to check the amount of iron in your blood and body
- A peripheral blood smear to see if your red blood cells are an abnormal shape
What lab do you use to check for anemia?
Tests for iron deficiency anemia
- Complete blood count. A complete blood count (CBC) test is important for many blood-related issues. ...
- Serum iron test. A serum iron test measures how much iron is in the blood. ...
- Ferritin test. A ferritin blood test measures the amount of ferritin in the blood. ...
- Total iron binding capacity. ...
- Soluble transferrin receptor. ...
- Peripheral smear. ...
Which lab test findings suggest anemia?
This topic will discuss about laboratory investigations for the differential diagnosis of MBA from those conditions, along with some preliminary investigations. Hematological Tests 1. Hemoglobin and Hematocrit. According to WHO, the criteria for anemia is when adult males have Hemoglobin levels 13 g/dL and adult females have 12 g/dL. As the iron deficiency worsens, both Hb and PCV decline together.
Which laboratory finding is indicative of anemia?
The outlook depends on the underlying cause of the disease and whether symptoms are managed appropriately and in a timely manner. Death as a result of autoimmune hemolytic anemia is rare. [2] If you need medical advice, you can look for doctors or other healthcare professionals who have experience with this disease.
What is the prognosis of hemolytic anemia?

What labs are abnormal with hemolytic anemia?
Haptoglobin, bilirubin, and liver function tests. A low level of haptoglobin in the bloodstream is a sign of hemolytic anemia. Hemoglobin is broken down into a compound called bilirubin. High levels of bilirubin in the bloodstream may be a sign of hemolytic anemia.
What is the hallmark of hemolytic anemia?
The hallmark of hemolysis is shortened red blood cell survival in the peripheral blood. Hemolysis results in anemia only when bone marrow cannot keep up with the rate of red cell destruction. Even though anemia is very commonly observed in most cancer patients, hemolytic anemias are rather rare.
What test confirms hemolytic anemia?
A test called a complete blood count (CBC) can help diagnose anemia and offer some hints to the type and cause of the problem. Important parts of the CBC include red blood cell count (RBC), hemoglobin, and hematocrit (HCT). These tests can identify the type of hemolytic anemia: Absolute reticulocyte count.
Is iron low in hemolytic anemia?
An interstitial deletion of the chromosome 13 was found in the medullar karyotype. PNH through chronic intravascular hemolysis induces an urinary iron loss. This is the only cause of hemolytic anemia inducing iron deficiency.
How is autoimmune hemolytic anemia diagnosed?
How is autoimmune hemolytic anemia diagnosed? Your healthcare provider will recommend a complete blood count (CBC) to look for warning signs of anemia. Specifically, this test measures: How many red blood cells, white blood cells and platelets you have.
How do you evaluate hemolytic anemia?
When anemia is identified, testing should include measurement of lactate dehydrogenase, haptoglobin, reticulocyte, and unconjugated bilirubin levels, as well as urinalysis (Table 3). Lactate dehydrogenase is intracellular, and levels increase when RBCs rupture.
Which test suggests autoimmune hemolytic anemia if positive?
Autoimmune hemolytic anemia is diagnosed by detection of autoantibodies with the direct antiglobulin (direct Coombs) test (see figure Direct Antiglobulin Test ). Antiglobulin serum is added to washed RBCs from the patient; agglutination indicates the presence of immunoglobulin or complement (C) bound to the RBCs.
Why MCV is high in hemolytic anemia?
Folate consumed during chronic hemolysis may lead to megaloblastosis and a high MCV. However, the MCV also may be elevated in patients with high reticulocyte counts since these cells are larger than mature RBCs.
What are the signs and symptoms of hemolytic anemia?
Signs and Symptoms of Hemolytic AnemiaJaundice. Jaundice refers to a yellowish color of the skin or whites of the eyes. ... Pain in the Upper Abdomen. Gallstones or an enlarged spleen may cause pain in the upper abdomen. ... Leg Ulcers and Pain. ... A Severe Reaction to a Blood Transfusion.
Is hemolytic anemia Normocytic or Macrocytic?
Hemolytic anemia is classified as normocytic anemia with an MCV of 80 to 100 fL. It is a form of low hemoglobin due to the destruction of red blood cells, increased hemoglobin catabolism, decreased levels of hemoglobin, and an increase in efforts of bone marrow to regenerate products.
What are the 5 symptoms of hemolytic uremic syndrome?
What are the symptoms of hemolytic uremic syndrome? Symptoms of HUS include vomiting, bloody diarrhea (loose stool/poop), stomach pain, fever, chills, and headache. As infection progresses, persons may experience fatigue, weakness, fainting, bruising, and paleness.
What is the difference between anemia and hemolytic anemia?
Hemolytic anemia is a sub-type of anemia, a common blood disorder that occurs when the body has fewer red blood cells than normal. In hemolytic anemias, the low red blood cell count is caused by the destruction — rather than the underproduction — of red blood cells.
How does extrinsic hemolytic anemia develop?
Extrinsic hemolytic anemia develops by several methods, such as when the spleen traps and destroys healthy red blood cells, or an autoimmune reaction occurs. It can also come from red blood cell destruction due to:
What is the term for anemia that is caused by the red blood cells?
Intrinsic hemolytic. Intrinsic hemolytic anemia develops when the red blood cells produced by your body don’t function properly. This condition is often inherited, such as in people with sickle cell anemia or thalassemia, who have abnormal hemoglobin.
What causes extrinsic hemolytic anemia?
Underlying causes of extrinsic hemolytic anemia include: HELLP syndrome (named for its characteristics, which include hemolysis, elevated liver enzymes, and low platelet count) In some instances, hemolytic anemia is the result of taking certain medications. This is known as drug-induced hemolytic anemia.
What causes hemolytic anemia in children?
The causes are similar to those found in adults and include: infections .
What is the most severe form of hemolytic anemia?
rifampin (Rifadin) One of the most severe forms of hemolytic anemia is the kind caused by receiving a red blood cell transfusion of the wrong blood type. Every person has a distinct blood type (A, B, AB, or O).
What are the treatment options for hemolytic anemia?
Treatment options for hemolytic anemia may include: red blood cell transfusion. IVIG. immunosuppressants.
How to tell if you have hemolytic anemia?
Diagnosing hemolytic anemia often begins with a review of your medical history and symptoms. During the physical exam, your doctor will be checking for pale or yellowed skin. They may also press gently on different areas of your abdomen to check for tenderness, which could indicate an enlarged liver or spleen.
What causes hemolytic anemia?
There are 2 main types of hemolytic anemia: inherited and acquired. Different diseases, conditions, or factors can cause each type:
How is hemolytic anemia diagnosed?
Your healthcare provider may think you have hemolytic anemia based on your symptoms, your medical history, and a physical exam. Your provider may also order the following tests:
How long does hemolytic anemia last?
A severe reaction to a blood transfusion. Some types of acquired hemolytic anemia are short-term (temporary) and go away over several months. Other types can become lifelong (chronic). They may go away and come back again over time.
How to prevent hemolytic anemia?
For example, cold weather can often trigger the breakdown of red blood cells. To protect yourself, avoid the cold, wear warm clothes, and keep your home warmer.
What is it called when you have a lower amount of blood?
Red blood cells carry oxygen to all parts of your body. If you have a lower than normal amount of red blood cells, you have anemia. When you have anemia, your blood can’t bring enough oxygen ...
What does it mean when a parent passes on hemolytic anemia?
Inherited hemolytic anemia means that parents pass the gene for the condition on to their children.
What does CBC mean in blood work?
Complete blood count (CBC). This test measures many different parts of your blood. Other blood tests. If the CBC test shows that you have anemia, you may have other blood tests. These can find out what type of anemia you have and how serious it is.
What does it mean when your bilirubin is high?
High levels of bilirubin in the bloodstream may be a sign of hemolytic anemia. High levels of this compound also occur with some liver and gallbladder diseases. Thus, you may need liver function tests to find out what's causing the high bilirubin levels. Hemoglobin electrophoresis.
Why do hemolytic anemia patients have high reticulocyte counts?
People who have hemolytic anemia usually have high reticulocyte counts because their bone marrow is working hard to replace the destroyed red blood cells. Peripheral smear.
What is the chemical that breaks down hemoglobin?
When red blood cells break down, they release hemoglobin into the bloodstream. The hemoglobin combines with a chemical called haptoglobin. A low level of haptoglobin in the bloodstream is a sign of hemolytic anemia. Hemoglobin is broken down into a compound called bilirubin.
What is the first test for anemia?
Complete Blood Count. Often, the first test used to diagnose anemia is a complete blood count (CBC). The CBC measures many parts of your blood. This test checks your hemoglobin and hematocrit (hee-MAT-oh-crit) levels. Hemoglobin is an iron-rich protein in red blood cells that carries oxygen to the body.
What is the physical exam for hemolytic anemia?
Physical Exam. Your doctor will do a physical exam to check for signs of hemolytic anemia. He or she will try to find out how severe the condition is and what's causing it. The exam may include: Checking for jaundice (a yellowish color of the skin or whites of the eyes)
What test is done to determine if you have hemolytic anemia?
Peripheral smear. For this test, your doctor will look at your red blood cells through a microscope. Some types of hemolytic anemia change the normal shape of red blood cells.
What to do if you have hemolytic anemia?
If your hemolytic anemia is inherited, you may want to consult a genetic counselor. A counselor can help you understand your risk of having a child who has the condition. He or she also can explain the choices that are available to you.
What is the enzyme that converts lactate to pyruvic acid?
Lactate dehydrogenase (LDH or LD) is an enzyme found in nearly all living cells (animals, plants, and prokaryotes). LDH catalyzes the conversion of lactate to pyruvic acid and back, as it converts NAD+ to NADH and back. A dehydrogenase is an enzyme that transfers a hydride from one molecule to another.
Why is LDH high in blood?
In Hemolysis, LDH is high in blood simply because many cells inside the intravascular space are being destroyed (hemolysis) and their insides spewing into the intravascular space together with the LDH inside them.
What is the haptoglobin assay used for?
In clinical settings, the haptoglobin assay is used to screen for and monitor intravascular hemolytic anemia.
What is the protein that is encoded by the HP gene?
Haptoglobin (abbreviated as Hp) is the protein that in humans is encoded by the HP gene. In blood plasma, haptoglobin binds free hemoglobin (Hb) released from erythrocytes with high affinity and thereby inhibits its oxidative activity.
Does extravascular hemolysis release haptoglobin?
Conversely, in extravascular hemolysis the reticuloendothelial system, especially splenic monocytes, phagocytose the erythrocytes and hemoglobin is relatively not released into circulation; however, excess hemolysis can release some hemoglobin causing haptoglobin levels to be decreased.